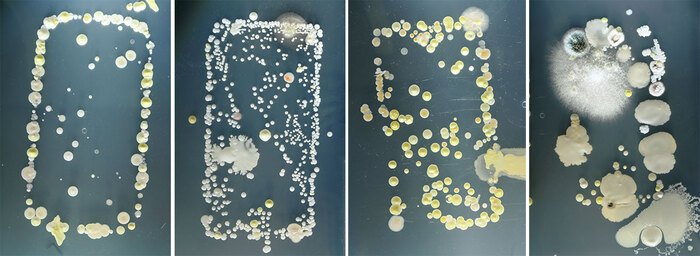

Продолжение поста «У кисы умерла пожилая хозяйка, а родные не пустили ее домой. Сейчас она двое суток в стационаре после стерилки. СПб и ЛО. Тосно»6
Всем привет от Зеленоглазки. Она дома. Огромное спасибо всем за помощь, поддержку. Она стояла на платном пиаре и в это время находилась на стационаре в клинике. Домой поехала уже стерилизованная и с первой прививкой. Домой поехала в Колпино. Там у нее есть мохнатые друганы - собака и кошка. Все у нее хорошо. Я больше всего переживала за лоток, но все прошло отлично - она сразу же поняла, как им пользоваться в новом доме.
Еще раз большое спасибо, всех обнимаю, одна бы я никогда не справилась.
Топ-3 крутых коллаборации XBOX
Компания Microsoft не редко коллаборирует с известными брендами, я был приятно удивлен, когда увидел уже выпущенные консоли Xbox в необычных для себя стилях. Итак, топ 3 реально крутых и необычных коллаборации Xbox:
3. В 2020 году Microsoft показала тизер коллаборации между Xbox One и брендом баскетболиста Майкла Джордана. Помимо Xbox и пары джойстиков с логотипом Air Jordan, в набор положили лимитированные кроссовки Air Jordan 3 Retro SE Unite в расцветке Fire Red. Красиво, ничего не скажешь.
2. Сразу три компании поучаствовали в следующей коллаборации - Xbox, Burberry и Minecraft. Всего было выпущено 50 штук, купить данную консоль было невозможно — гаджет разыгрывали на официальном сайте Burberry
1. Xbox и Oreo. Пожалуй, это одно из самых необычных сотрудничеств. Пользователи в интернете уже подметили схожесть консоли с PS5. Не знаю как вам, я бы с радостью обзавелся такой печенькой.
Еще больше интересных постов в нашем Telegram-канале: https://t.me/liltaverna
Напоминание от биолога
В связи с началом нового сезона ОРВИ и других заболеваний хотел бы как биолог напомнить людям о необходимости по приходу с улицы не только мыть руки, но и обрабатывать дезинфицирующим раствором или спиртовой салфеткой Ваш мобильный телефон и другие носимые устройства (павербанки, наушники и т.д.).
Корпуса мобильных телефонов оказались усеяны плотным слоем бактерий, среди которых присутствовал даже золотистый стафилококк, который переносят на себе до 20% населения Земли. Но если одни люди его могут не бояться, то у граждан, например, с ослабленным иммунитетом он может вызвать всё что угодно — от лёгкого кожного заболевания до менингита. Учёные сделали вывод, что на мобильном телефоне количество бактерий было в 5 раз выше, чем на сиденье унитаза или на подошве обуви.
Ссылка на исследование, где исследовались бактерии на поверхности мобильных телефонов медицинских работников:
От себя добавлю, что тут речь идёт только о бактериях, количество вирусных частиц подсчитать намного сложнее, но уверен их счёт так же идёт на тысячи или даже сотни тысяч.
Как менять образ жизни в лучшую сторону и делать это успешно?
#лонгрид. Все чаще можно встретить мысль о том, что только смена образа жизни влечет за собой желаемые внешние изменения с устойчивым результатом. Эпизодические похудения и тренировочные вспышки либо ни к чему не приводят, либо к разочарованию и откату к прежним значениям. Но как менять этот образ? Есть ли стандартизированный метод, когда по инструкции делаешь «раз, два, три» и жизнь начинает меняться?
Чтобы как с похудением. Для снижения веса определи свою суточную норму калорий, создай дефицит, сделай диету устойчивой и сбалансированной, придерживайся ей большую часть времени.
Или с тренировками: прогрессивные силовые нагрузки, достаточное потребление белка и восстановление.
Возможно, что такой метод есть.
Его описывает одна публикация, которая изучала поведение людей, которые ходили в Центры ЗОЖ (это такая гос. программа в Норвегии).
В течение года за людьми наблюдали, периодически их интервьюировали и вытаскивали разные ценные смыслы. Скомбинировав их, получилось что-то вроде рецепта.
Это не истина. А многие, перейдя на исследование вполне справедливо докапаются к выборке участников (всего 14 человек).
Однако, эта работа заинтересовала меня тем, что многие пункты мэтчились с моим тренерским опытом. Многие идеи оттуда я уже в течение нескольких лет продвигаю, как подход. Обычно, после прочтения исследований долго бьешься об заклад с мыслью "и как это применять?" Но в этот раз такого не было, все описано практично. Думаю, что какую-то схему действий и уверенность в своих силах это вам даст.
А если у вас есть свою трюки и лайфхаки, успешные личные кейсы по смене образа жизни, тогда делитесь ими в комментариях. Мне будет полезно почитать и рассмотреть для практики.
Мотивация.
Работа разделена на три большие темы с подтемами. Первая тема повествует о мотивации.
Мотивация не постоянна и рассчитывать на нее всецело будет недальновидно. Это волнообразная кривая, которая может бросать из крайности «нужно прямо сейчас« в крайность »да пошло оно все».
Научиться не уходить в крайности будет ценным приобретением. И тут вам помогут два подхода: обретение автономной мотивации и смена среды с обретением сообщества.
1а. Обрети автономную мотивацию.
Ученые разделили людей по двум типам мотивации: с автономной мотивацией и контролируемой. Обе они работают и приводят к изменениям, однако контролируемая мотивация менее надежна.
Контролируемая мотивация — это изменения проходящие в ответ на внешнее давление. Самыми частыми внешними мотиваторами исследователи отметили: пожелание супруга или члена семьи, рекомендации врача по смене образа жизни. А так же влияние культуры, общества, которые задают критерии внешнего вида и медийность.
Люди отмечали, что при снижении внешнего давления или вообще устранении этого фактора, поддерживать дальнейшие изменения им становилось труднее, кто-то и вовсе останавливался.
Автономная мотивация называется так, потому что изменения побуждаются внутренними мотивами, независимо от внешних условий. Эти мотивы личностно важные и ценны для хорошей жизни, а не для достижения привлекательного образа или для соответствия чьим-то ожиданиям.
Можно контролировать себя, держать себя в рамках внешнего давления, постоянно убеждать себя « мне это надо», но это быстро превратиться в выматывающее занятие. Продуктивность снижается, в следствие чего идет стагнация результата, желание продолжать все уменьшается. Тогда начинаются срывы и отходы от здорового режима на месяцы, а то и годы, а затем эпичные возвращения.
Обрести внутреннюю мотивацию в данном случае будет наилучшим решением. В чем будет твоя мотивация, знаешь только ты. Я, как тренер, слышал много удивительных и неожиданных мотиваций. Несмотря на это, они работали и подогревали желание тех, кто дорожил этими ценностями. Обрети свою мотивацию. Так ты быстрее придешь к автоматизму без надобности постоянного контроля.
1б. Смени среду и найди сообщество.
Изменение среды и сообщества, поиск единомышленников так же необходимы.
Среда и сообщество служат местом, где ты будешь получать компетенции и знания по здоровому образу жизни, без которых далеко не уедешь. В этом плане с интернетом нам всем проще. Главное находить объективные источники информации.
Со средой посложнее. Нездоровый образ жизни часто имеет социальную подоплеку. Мы ведем себя так, как принято в нашем окружении. Есть много историй о том, как смена образа жизни приводила к полной смене окружения. Хорошо это или плохо, не мне решать. Но факт остается фактом. Часто наше нездоровое поведение — это отражение привычек сообщества и окружения, а не только наших личных привычек. Поэтому найди место, среду, сообщество, где ты будешь проявлять себя иначе, где ценится иное поведение, а выдающимся считается здоровое отношение к себе. Тебе нужно туда.
Так же в сообществах ты будешь получать поддержку в моменты эмоциональной нестабильности.
Многие на этом этапе обращаются к тренерам, которые закрывают и необходимость получать информацию о ЗОЖ, и выступают в роли поддержки, и той среды, в которой ценятся ЗОЖные качества.
Эмоциональное равновесие.
Будет очень недальновидно с твоей стороны надеяться, что весь трансформационный период у тебя будет суперская мотивация, все гладко и ровно. Ведь ты хочешь меняться, значит будешь! Нет😅
Рано или поздно ты столкнешься с трудностями: стресс, плохая самооценка, болезни, травмы, проблемные отношения, одиночество, депрессия и другие негативные жизненные события.
Все это вносит эмоциональный раздор, переключает внимание и снижает увлеченность ЗОЖ. Поэтому необходимо выработать стратегию поведения, для уравновешивания эмоциональной составляющей.
2а. Измени способ мышления.
Позитивная визуализация и снижение катастрофичности мышления. Если твое воображение привыкло рисовать наихудшие сценарии развития, культивируя тревогу, тебе необходимо научиться переключаться на позитивную визуализацию. Наоборот, представлять, как много хорошего ты уже сделал/а и будешь продолжать делать. Всегда вспоминай, какие бонусы ты уже получил/а и как гордишься собой за то, что работаешь над своим здоровьем. Помни, что сам факт того, что ты уже начал/а следить за здоровьем, это уже достижение в любой момент времени. Не обесценивай его.
Перестань заниматься самобичеванием. «Я ничего не смогу», «У меня как всегда ничего не получится», «Да я же знаю себя — сдамся через неделю» — это моральное истязание себя и самозакапывание точно не приводит к чему-то созидательному. Мысль о том, что «у кого-то получилось, получится и у меня» более вдохновляющая. Ты ничем не хуже.
Избавься от дихотомического (черно-белого) стиля мышления. «Я съел/а шоколад/выпил алкоголь, значит предыдущие три недели диеты были испорчены”. «Я пропустил неделю тренировок, есть ли смысл мне возвращаться к ним?» И так далее. На мой взгляд, это одна из самых губительных ошибок. (Подробнее про такой стиль мышления писал у себя в блоге, присоединяйся.)
В трансформации нет ничего однозначно хорошего и однозначно плохого.
Главное — это направление движения. И только ты решаешь, продолжаешь ты двигаться в нужном направлении или нет.
Если решишь, что шоколадка закончила твою диету, значит так оно и есть. Если решаешь, что шоколадка — часть твоей диеты и ничего страшного не случилось, значит так оно и есть.
2б. Ставьте реалистичные цели.
Многие ставят себе цели в килограммах за n месяцев, находят привлекательный образ кумира, которому хочется соответствовать и начинают работать.
Предсказать прогресс в килограммах и по времени совершенно невозможно, потому что невозможно предсказать условия, в которых человек будете меняться и генетику. Поэтому такая цель обманчива и в какой-то момент можно подумать, что и не достижима, если не удается прийти к ней за отведенное время. И мотивация, построенная на основе этой цели, начинает угасать.
Ставьте цели, которые легко выполнять. Не набрать мышц, а «делать три качественные тренировки в неделю на протяжении 6 месяцев».
И если у тебя в графике стоит тренировка, не нужно спрашивать себя «а готов/а ли я?” , “а не будет ли мне тяжело сегодня, я устал/а?” , »вдруг я не успею”. Всегда приходи на занятие, а если по ходу тренировки реально становится тяжело и плохо, только тогда заканчивай ее. Но прийти ты должен/на в любом случае.
2в. Осознанное питание.
Переставай исключать продукты или их категории из своего рациона. Путем исключения ты сразу ставишь себя в положение обделенности, в котором трудно находиться, особенно в условиях окружающего изобилия.
Вместо этого расширяй продуктовую корзину, экспериментируй, пробуй новое. Пользуйся тем разнообразием, которое предлагает пищевая индустрия, но с уклоном в цельные, непереработанные продукты. В твоем рационе должны быть и овощи, и рыба, и конфеты, и цельное мясо, молочная продукция, и овощи, и пицца, и фрукты. Конечно, выбор должен диктоваться и вкусовыми пристрастиями.
2г. Освободись от чувства стыда.
А точнее не думай о своем несоответствии стандартам общества. Следуй внутренним критериям и оценкам. Это будет важным шагом к автономной мотивации.
Навыки самоконтроля.
Это третий столп нового образа жизни, который был отмечен исследователями. Этот большой пункт они тоже разделили на три подпункта.
Цели.
Многие начинают здоровое питание и тренировки как способ контроля или снижения веса. И в целом это супер. Это как маркетинговая воронка, которая захватывает как можно больше людей с похожими широким запросом, но в последствии переводит их все дальше к глубокому и индивидуальному запросу.
Однако исследователи заметили, что в течение года в Школе здорового образа жизни, участники стали рассматривать изменения в образе жизни как неотъемлемую ценность, хотя изначально они начинали только для того, чтобы снизить вес.
Да, я много пишу о том, что хорошая фигура — это бонус к образу жизни. Но не обязательно именно с этого начинать. Работает и тот случай, когда двидешься от обратного. Желание стать красивым перерастет в образ жизни. Надо только найти путь.
Что бы это получилось, рассматривай качество тела как результат изменения поведения в отношении своего здоровья.
Создание пространства для нового поведения.
Под созданием пространства в исследовании подразумевалась необходимость выделять больше времени новым привычкам. Если его не будет, ты будешь постоянно возвращаться к привычному поведению.
«Как надоело выбирать, что мне съесть на ужин!» Знакомый многим напряженный момент. И очень нестабильный.
Это состояние — грань, между новым непривычным поведением и старым способом решения. Если его не обуздать, ты соскочишь и сделаешь то, что просто, быстро и не энергозатратно. И, как правило, это еще и очень калорийно.
Тебе нужно смириться с тем, что ты будешь тратить больше времени на чтение этикеток, или взвешивание и запись еды, на обдумывание ужина и рациона на следующий день, на поиск белковых продуктов или более сбалансированных перекусов. Все это будет, как не крути. Если будешь этого избегать, будешь попадать в паутины быстрых решений.
Точнее не просто смириться, а сознательно выделить себе на это время, обозначить границы. Это время для твоего здоровья.
Концентрация на позитивном.
Ищите удовольствие от движения вперед и процесса. От осознания того, что вы меняете образ жизни. Не концентрируйтесь на конкретном результате, а поглядывайте на него.
Начало работы над собой — это уже позитивные изменения, и они всегда таковыми будут, даже если прошло со старта уже пол года. Это то, чем все равно можно гордиться.
Итог.
Пунктов много. Как и работы. Начинай с того, что показалось тебе наиболее простым и быстро применимым в твоих жизненных условиях.
Надеюсь, что это направит тебя в нужное тебе направление. Успешного пути!
Если тебе нравится мой контент, можешь продолжать читать мои посты здесь, а можешь подписаться на мой Телеграм канал Терентьев Фитнес. Там ты найдешь больше контента на тему, фитнес атмосферу, много разумных и применимых к жизни рекомендаций по питанию и тренировкам. И чуть-чуть о закулисной жизни профессионального спортсмена, который справляется с травмами и готовится к Олимпийским играм.